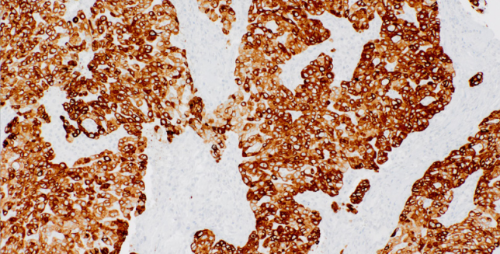

Cytokeratin 7/8 Mouse Monoclonal Antibody(ARM979)
CAT.NO. : ARM6769
RMB Please choose
RMB Please choose
Size:
Trail, Bulk size or Custom requests Please contact us
*产品价格可能会有所调整,请以品牌方官网实时更新的价格为准,以确保准确性。
Background
Anti-cytokeratin 7/8, is expressed in majority of epithelial tumors, including lung, liver, pancreas, Gastro-Intestinal tract, breast, genitourinary system, female reproductive organs and some endocrine organs. Similar to Cytokeratin (AE1/AE3) antibody cocktail, cytokeratin 7/8 may stain astrocytic tumors, but cross-reactivity is lower.
Application
|
Application |
Dilution Ratio |
|
IHC |
1:50 - 1:200 |
Overview
|
Isotype |
Mouse IgG2a+Rabbit IgG |
|
Host |
Mouse |
|
Species Reactivity |
Human |
|
Purity/Purification |
Purified |
|
Form/Format |
Tris Buffer, pH 7.3 - 7.7, with 1% BSA and <0.1% Sodium Azide |
|
Immunogen |
Cocktail |
Data
Immunohistochemical staining of human lung tissue using Cytokeratin 7/8 Mouse Monoclonal Antibody (ARM979).
Storage
Store at -20°C. Stable for one year from the date of shipment.
Research Use Only
For Research Use Only. Not for use in diagnostic procedures.
New Products
